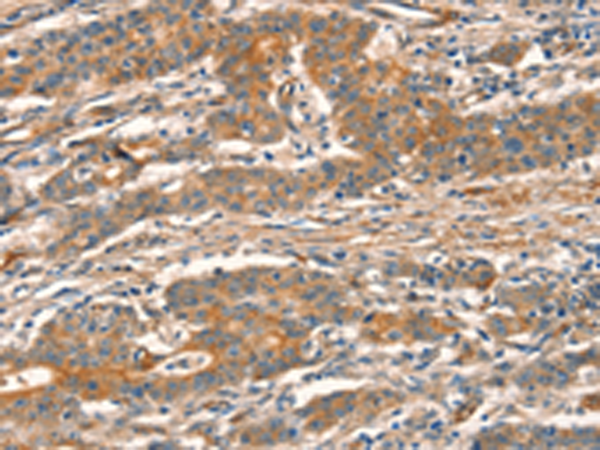
一抗

|
Background: |
CUEDC2 is involved in ubiquitin- and proteasome-mediated degradation of progesterone receptor and estrogen receptor (ER)-alpha.CUEDC2 reduced PRB protein content and promoted progesterone-induced PRB degradation via the ubiquitin-proteasome pathway. |
|
Applications: |
ELISA, IHC |
|
Name of antibody: |
CUEDC2 |
|
Immunogen: |
Fusion protein of human CUEDC2 |
|
Full name: |
CUE domain containing 2 |
|
Synonyms: |
C10orf66; bA18I14.5 |
|
SwissProt: |
Q9H467 |
|
IHC positive control: |
Human gastric cancer and human thyroid cancer |
|
IHC Recommend dilution: |
50-200 |

 購物車
購物車 幫助
幫助
 021-54845833/15800441009
021-54845833/15800441009